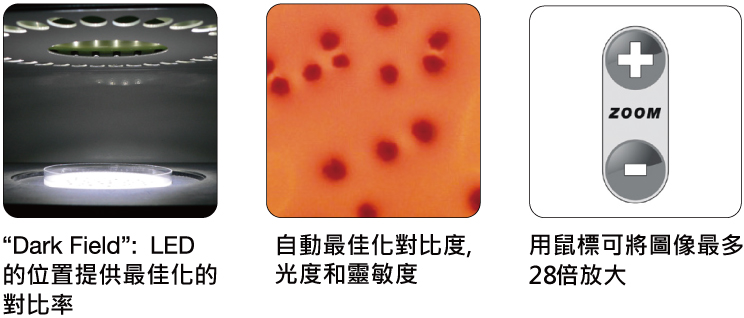

Scan®全自動計數器&抑菌圈分析儀
Scan自動菌落計數器提供高效、全面和精確的菌落計數,
抑菌圈測量儀可保證更快,更準確的測量,同樣也可保證結果的可追溯。。


瞬間得到結果
由於培養皿實況影像能夠在計算機上呈現出来 , 計數多與1000CFU/秒,每一個被計數的菌落都会被標記,其結果都會被自動地保存。
.jpg)
預設參數
在列表中選擇預設培養基參數
Scan®1200還可以檢測:
- MC-Media PadsTM: AC, CC, EC/CC, SA
- PetrifilmTM: AC, ETB, CC, EC/CC, EC
- Compact DryTM: TC, CF, EC, ETB
- easy PlateTM: AC, CC, EC, SA
高性能的菌落計數
Scan®適合任何類型的菌落,Scan®1200可計數的最小菌落为0.05mm, Scan®500 和Scan®300可計數的最小菌落 为0.1mm,菌落計數器能自動分離融合性的菌落,可以創造多邊形區域以便排除培養基的缺陷及空氣泡。你也可以手工增加或移動菌落,每一個改變都會自動地保存在報告中。

顏色的識別及顯色培養基
Scan®500及Scan®1200均可讀取顯色培養基並通過顏色來區分不同的菌落:即使同一個培養皿上有7種不同顏色的菌落,顏色選擇可以直接從細菌的顏色中選,可調節顏色靈敏度。
.jpg)
高性能及其靈活性
Scan®500及Scan®1200能夠高效率的工作,因為你可以創建和編輯一系列的抗生素,這對於常規性的分析很用處,用Scan®1200測量抑菌圈可以確保分析和診斷可靠性和重現性
• 快速檢測:點擊一下,即刻檢測高達7種抗生素的敏感性
• 可以手動增加或刪除抑菌圈,抑菌區域可以手動調整大小

醫藥學分析
抑菌圈測量能夠讓你在微生物領域測試抗生素的功效, 從而快速診斷,準確選擇一個適當的抗生素對症下藥。Scan®有一個内置的抗生素數據庫。數據庫涵蓋了法國微生物學(CA-SFM),歐洲藥敏測試委員會(EUCAST) 以及臨床和實驗室標準協會(CLSI)的各項標準。通過檢測可以得出細菌對抗生素的敏感性。這個數據庫是完全可編輯的。
製藥學分析
在製藥工業當中,Scan®能夠使你在生產過程中通過測試抑菌圈進而測試抗生素的質量,培養基擴散的測量能夠讓你評估抗生素的作用。
.jpg)
列印結果
可以輸出數據到電腦,存檔为 ExcelTM,PDF,SCA或BIO格式。也可以從照相機中以JPEG,PNG,BMP格式輸出圖片。
最佳可視化
良好的菌落視覺與”Dark Field”技術是無法比擬的(雙斜切線和交叉對光反射),高清晰度的實況影像及圖像的自動最佳化(亮度、
對比度、敏感度)。你也可以利用數位變焦檢查一些主要區域。

Scan®全自動計數器&抑菌圈分析儀

Scan® 300
• CMOS 彩色照相機,28次變焦,M12鏡頭, 分辨率100萬像素
• 6種燈光和背景组合
• 自動調節背景顏色
• 亮度、對比度和靈敏度由軟體自動最佳化
• 可檢測菌落最小直徑:0.1毫米
• 自動分離成片菌落
• 創建多邊形工具
• LED燈使用壽命長
• 以Excel™, PDF 輸出數據, jpg, xls, png, bmp, 可重複計數文件
• 軟體有法語,英語,日語,漢語,俄語,西班牙語,德語
• 與數據鏈接可追溯系統兼容
• 符合 CFR21 part 11: 加密審計追蹤, 3級用戶管理
.jpg)

Scan® 500
• CMOS 彩色照相機,28次變焦,M12鏡頭, 分辨率100萬像素
• 6種燈光和背景组合
• 自動調節背景顏色
• 亮度、對比度和靈敏度由軟體自動最佳化
• 可檢測菌落最小直徑:0.1毫米
• 自動分離成片菌落
• 創建多邊形工具
• LED燈使用壽命長
• 以Excel™, PDF 輸出數據, jpg, xls, png, bmp, 可重複計數文件
• 軟體有法語,英語,日語,漢語,俄語,西班牙語,德語
• 與數據鏈接可追溯系統兼容
• 符合 CFR21 part 11: 加密審計追蹤, 3級用戶管理
• CLSI, EUCAST和CA-SFM數據庫抑菌圈分析
• 在一個培养皿上檢測和計算7種不同顏色菌落


Scan® 1200
• 6種燈光和背景组合
• 自動調節背景顏色
• 亮度、對比度和靈敏度由軟體自動最佳化
• 自動分離成片菌落
• 創建多邊形工具
• LED燈使用壽命長
• 以Excel™, PDF 輸出數據, jpg, xls, png, bmp, 可重複計數文件
• 軟體有法語,英語,日語,漢語,俄語,西班牙語,德語
• 與數據鏈接可追溯系統兼容
• 符合 CFR21 part 11: 加密審計追蹤, 3級用戶管理
• CLSI, EUCAST和CA-SFM數據庫抑菌圈分析
• 同一培養皿可檢測7種不同顏色+排除一個顏色
• 可檢測菌落最小直徑:0.05mm
• HD 彩色照相機,28倍變焦,HD日本鏡頭, 分辨率120萬像素


Scan® 4000
• 軟體自動最佳化光亮,對比度和靈敏度
• 自動分離黏合菌落
• 可創建多邊形排除區域
• 以Excel™, PDF 輸出數據, jpg, xls, png, bmp, 可重複計數文件
• 軟體有法語,英語,日語,漢語,俄語,西班牙語,德語
• 與數據鏈接可追溯系統兼容
• 符合 CFR21 part 11: 加密審計追蹤, 3級用戶管理
• CLSI, EUCAST和CA-SFM數據庫抑菌圈分析
• 同一培養皿可檢測7種不同顏色+排除一個顏色
• 可檢測最小菌落直徑: 0.05 mm
• 7種光源和背景的結合
• 超清彩色 CCD 相機,69 倍變焦, 超清日本鏡頭, 500 萬分辨率
• 可計數55-150 mm圓形培養皿和120 mm方形培養皿
• 黑/白背景無易損件
• 白色LEDm圓頂光源:無反射和陰影
• 可計數培養皿100%面積
• SIL/LIMS雙向連接


